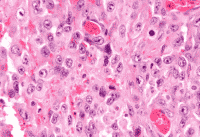
Epithelioid Mesothelioma Cells Under Microscope
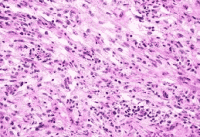
Sarcomatoid Mesothelioma Cancer Cells Under Microscope

Mesothelioma Cell Types
Mesothelioma’s three main cell types are Epithelioid, Biphasic, and Sarcomatoid. The most frequent type, epithelioid, has the greatest prognosis, whereas sarcomatoid is uncommon and has the worst prognosis. The proportion of each cell type in biphasic determines the prognosis. Each cell types determine the patient’s treatment options.
Home » Leading National Mesothelioma Law Firm » Mesothelioma Cancer » Mesothelioma Cell Types
Besides the location, mesothelioma is also characterized by cell type. The mesothelioma cell type of a patient’s cancer has a significant impact on prognosis and treatment options.
Cell Types of Mesothelioma
Mesothelioma is classified into cell types based on certain characteristics of the cancer cells. There are three primary cell types of mesothelioma:

The cell type is determined using a tissue sample from a biopsy. This is sent to a laboratory, where a pathologist looks at it under a microscope. Based on various characteristics of the cells, including their shape and size as well as how they interact with other cells, the cell type will be determined.
The pathologist also uses various types of tests to look for the presence of particular proteins in the sample. Depending on the appearance of the cells under the microscope, the pathologist will select which tests would be the most useful. These tests help ensure an accurate diagnosis since many different types of cancer cells can closely resemble each other in a tissue sample.
It’s important to determine the cell type accurately because it has a significant impact on the prognosis and treatment options for a particular patient.
Epithelioid Mesothelioma
Epithelioid is the most common cell type, representing approximately 60 percent of cases of pleural mesothelioma. Sometimes, this cell type is known as epithelial rather than epithelioid; these two terms mean the same thing in this context and can be used interchangeably. The characteristics of epithelial mesothelioma include:
Regularity of the cells
In epithelioid mesothelioma, all of the cells are approximately the same size and shape.
Square-shaped or columnar cells
which have a single nucleus in each cell. The nucleus is the part of the cell that houses the DNA and can be seen under a microscope as a spot inside of the cell.
Discrete sheets or clumps of cells
The cells of this cell type tend to stick together, causing them to form sheets or clumps. This means that the cancer doesn’t spread as easily around the body, and it’s also easier to remove surgically.
Rapid cell division
The cells of epithelioid mesothelioma tend to divide rapidly, which means that the tumor grows quickly.
There are a few subtypes of epithelioid mesothelioma, including tubulopapillary, adenomatoid and solid. These all share the same basic features but differ in the specific shapes of the cells and the structures that they form.
Epithelioid mesothelioma can closely resemble other types of cancer, including some common types of lung cancer and breast cancer. In some cases, epithelioid mesothelioma may be misdiagnosed as one of these cancers. Getting a second opinion on your diagnosis may be beneficial to ensure the right treatment plan can be created.
Sarcomatoid Mesothelioma
Sarcomatoid is a less common cell type, accounting for about 20 percent of cases of pleural mesothelioma. The characteristics of sarcomatoid mesothelioma cells include:
Irregular cell shapes
arcomatoid cells tend to vary in shape and size and are more irregular than epithelioid cells.
Spindle-shaped cells
The cells of this type are generally long and thin and tapered at both ends.
Small nodules or bundles of cells
Rather than forming larger sheets or clumps, sarcomatoid cells tend to be found in smaller groups. Unlike in epithelioid tumors, they generally don’t form glandular structures.
Slower cell growth
Sarcomatoid cells tend to divide less often than epithelioid cells do, so the tumor will generally grow at a slower rate.
Cells that separate easily
Sarcomatoid cells are less likely to stick together than epithelioid cells. They can more easily separate from each other, which allows them to spread more easily, both within the tissues of the area and more widely around the body. This characteristic accounts for the poorer prognosis associated with this cell type.
There are a few subtypes of sarcomatoid mesothelioma, including desmoplastic and lymphohistiocytoid. These share the overall features of sarcomatoid mesothelioma but differ in some specifics of cell and tissue structure.
Sarcomatoid mesothelioma can also closely resemble other types of cancer, including sarcomas, which are tumors that arise from connective tissue. Misdiagnosis can occur, and it may be beneficial for patients to seek a second opinion on their diagnosis before committing to a treatment plan.
Biphasic Mesothelioma
The biphasic cell type makes up the remaining 20 percent of pleural mesothelioma cases. In biphasic mesothelioma, there are cells with both epithelioid and sarcomatoid characteristics present in the same tumor. Overall, biphasic mesothelioma behaves in a way that’s intermediate between the epithelioid and sarcomatoid types.
The characteristics of biphasic mesothelioma include:
A mixture of epithelioid and sarcomatoid cells
which are present in the same tumor. The pathologist will see cells of both types when looking at the sample under the microscope.
At least 10 percent
of the tumor must be made up of each cell type in order for it to be diagnosed as biphasic. For example, if 95 percent of the cells in a tumor are epithelioid and only five percent are sarcomatoid cells, then it will be diagnosed as epithelioid, not biphasic. In this case, there are not enough sarcomatoid cells for them to be considered significant. However, if the tumor is 85 percent epithelioid and 15 percent sarcomatoid, then it will be diagnosed as biphasic.
The relative proportions of epithelioid and sarcomatoid cells will determine how biphasic mesothelioma will tend to behave. If the tumor is made up mostly of epithelioid cells, then it will tend to behave more like an epithelioid tumor, growing quickly but being less likely to spread. If it’s made up mostly of sarcomatoid cells with only a few epithelioid cells, then it may be more likely to spread within the local area and around the body, as a sarcomatoid tumor would do.
Prognosis by Cell Type
The cell type of mesothelioma has been shown to have a significant impact on a patient’s prognosis. In general, patients with epithelioid tumors have the best prognosis, while those with sarcomatoid tumors have a poorer prognosis.
Another study published in 2016 showed that the one-year survival rate for patients with epithelioid mesothelioma was 69 percent. For those with sarcomatoid or biphasic tumors, it was 29 percent.
Treatment can make a difference in life expectancy for mesothelioma patients, although the effectiveness of particular treatment options is also impacted by cell type. Patients with epithelioid mesothelioma tend to receive more benefit from certain treatment options than those with sarcomatoid tumors.
A 2018 study found that the median overall survival for patients with pleural mesothelioma was:

Treatment Options by Cell Type
When formulating a treatment plan for a patient with mesothelioma, the cell type is one factor that will be considered. Because epithelioid and sarcomatoid cells behave differently in the body, they will also respond differently to many treatments. In general, patients with the epithelioid cell type will tend to have more treatment options than those with the sarcomatoid cell type.
The cell type is not the only factor that’s used in determining a patient’s treatment plan. The location and stage of the cancer are also very important, as well as the patient’s age, general medical condition and preferences for treatment. Your treatment team will discuss with you what treatment options they recommend in your case and why.
Most patients with mesothelioma are treated with multimodal therapy, which involves using a combination of different treatment methods to eliminate as many cancer cells as possible.
Surgery
In many patients, surgery is used to remove as much of the cancer as possible. However, surgery is only effective in certain cases. Patients who are in a more advanced stage are often not candidates for mesothelioma surgery because their cancer is likely to have spread already.
Patients with epithelioid tumors are often good candidates for surgery as long as their cancer has been found in a relatively early stage. This is because epithelioid cells tend to stick together more closely, making them easier to remove through surgery. However, patients with sarcomatoid tumors are not as likely to respond well to surgery. Because sarcomatoid cells tend to spread apart from each other, some cancer cells are likely to be left behind after surgery.
A 2018 study found that surgery significantly improved survival for patients with epithelioid tumors, adding more than six months to their median life expectancy. However, for patients with sarcomatoid tumors, there was not a clear survival benefit. In this study, those with biphasic tumors also experienced a benefit, although it was smaller. Other studies have not found a benefit for surgery in patients with biphasic tumors.

Chemotherapy
Systemic chemotherapy, which is given to the whole body through an IV, is a common part of treatment for mesothelioma. This can be combined with surgery and may be given before or after the procedure. In those who are not candidates for surgery, systemic chemotherapy is often the first line of treatment. This includes patients with sarcomatoid mesothelioma.
A 2016 study showed that cell type has an influence on the likelihood of response to chemotherapy. Sixty-three percent of patients with epithelioid tumors showed a significant clinical response to chemotherapy, while only 45 percent of those with sarcomatoid tumors showed such a response. Although patients with epithelioid tumors showed a greater likelihood of benefit, chemotherapy is still often recommended as the first line of treatment in patients with sarcomatoid tumors, and there is a relatively good chance that they will respond to the treatment.

Other Treatment Options
While patients with sarcomatoid mesothelioma may not be candidates for surgery, they do still have other treatment options. For example, two different forms of immunotherapy are approved for use in pleural mesothelioma patients who are not candidates for surgery.
This includes many patients with sarcomatoid tumors. A device called Tumor Treating Fields, which uses electrical fields passed through the skin to affect the cells’ ability to divide, is also approved for use in pleural mesothelioma patients who are not candidates for surgery.
In addition, some patients may choose to participate in a clinical trial. This is a research study of a new treatment, or a new combination of existing treatments. Participating in a clinical trial is a way for some patients to potentially gain access to a cutting-edge treatment with the potential to extend life.
If you’re interested in exploring this option, you should discuss it with your oncologist to learn more about what’s involved.

